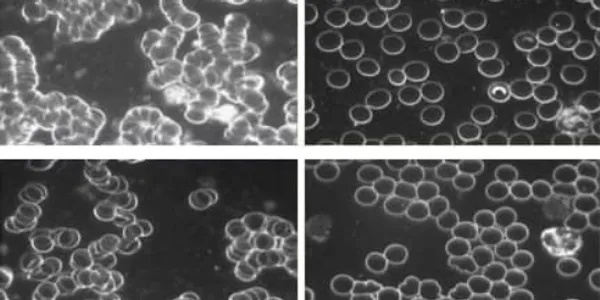
Blood viscosity comparison before and after grounding

TRANSFORMYOUR GAME
Discover how Earthing revolutionizes golf performance through scientifically proven grounding methods.

Reduced Inflammation
Reducing inflammation eases joint pain and stiffness, improving your golf swing range and mobility. Faster recovery from soreness allows you to stay in peak condition for your next round.

Enhanced Circulation
Improved circulation delivers oxygen and nutrients to muscles, helping you maintain energy throughout your round. Faster muscle recovery between golf swings keeps you playing at your best.

Stress Reduction
Lower stress levels promote a calm and focused mindset, helping you stay composed under pressure. A relaxed mental state improves your golf shot accuracy and overall enjoyment of the game.

Improved Balance
Better balance enhances your swing mechanics, giving you greater control and consistency. Improved stability helps you perform on uneven terrain and maintain your posture through each shot with the seven83 grounding golf shoe.

Mental Clarity & Focus
Clearer thinking aids in reading greens and planning your shots with precision. Enhanced focus and confidence keep you steady and competitive throughout your round. An earthing golf shoe is the missing link.

Boosted Immune Function
A stronger immune system keeps you healthy, reducing downtime and ensuring more time on the course. Staying resilient to illness means you can focus on improving your game.
PROVEN RESULTS
Clinical studies demonstrate the measurable benefits of grounding footwear
Inflammation Reduction
The left image shows intense areas of inflammation and pain, identified by the arrows. The right image was taken after two nights of grounded sleep. The patient had complained of intense chronic left low back pain and right shoulder pain that interfered with sleep, and waking stiff and sore in the previous four months. Prolonged medical treatment had not been successful.
After two nights of Earthing, he reported 50% less pain, 80% reduction in pain interfering with sleep, and 75% reduction in waking stiff and sore. After four weeks, he said his pain was totally gone with only occasional mild stiffness. He commented: "I have my life back."


Rapid Inflammation Resolution
Fig. 1. These thermal images, of a patient with pain in the area of both knees, were taken a half-hour apart − before (left) and after Earthing (right). Tissue damage generates heat, represented by the hot colors on the left. The difference shows a clear and rapid resolution of inflammation.
Grounding and Blood Viscosity
With respect to health benefits, it is known that grounding has a significant impact on blood viscosity. The images on the left are before grounding, and those on the right are 45 minutes after grounding. The images show significant thinning and decoupling of blood cells. Blood viscosity of the subjects was measured with a method called zeta potential, which measures the speed with which red blood cells migrate into an electric field.

Delayed Onset Muscle Soreness
Consistent with all measurements, ungrounded subjects expressed the perception of greater pain. Related to the pain finding was evidence of a muted white blood cell response indicating that a grounded body experiences less inflammation.
Experience the Seven83 Difference
Transform your golf game with grounding footwear backed by scientific research
Sign Up Now